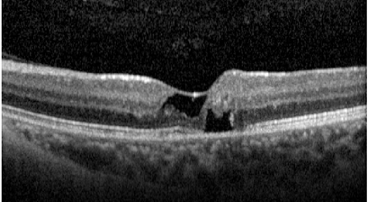
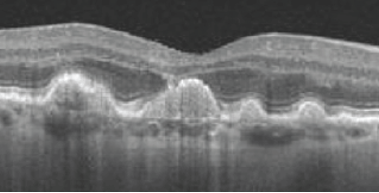
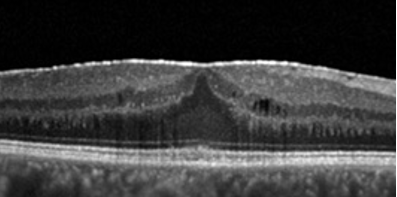
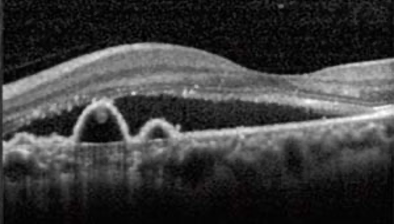

drusas duras

drusa mole

PED drusenoide

1-neovasos
2-atrofia geografica

memb neovascular

DMRI EXSUDATIVA - UMIDA

DMRI SECA

DMRI memb neovascular ativa

cictriz com fibrose-staining

mancha de tinta
serosa central

fumaça de chamine
serosa central

DR regmatogenico
rotura com operculo

DR regmatogenico
rotura com operculo

DR seroso
HARADA


retinosquise

pseudohipopio
oleo de silicone ficou branco ,emulsificou na CA


sempre verificar a posição da canula de infusão antes de injetar liquido,pois se ela tiver enre retina e coroide pode deslocar mais a retina
Paciente masculino, 8 anos, apresenta redução da acuidade visual somente no olho direito, há cerca de 2 meses.

Trata-se da doença de Coats, caracterizada por telangiectasias, microaneurismas e exsudação. É mais comum em homens com menos de 10 anos de idade e frequentemente é unilateral.
tto da doença de Coats
A fotocoagulação deve ser feita nas áreas de não perfusão para reduzir o risco de neovascularização e favorecer a reabsorção dos exsudatos.
A telangiectasia macular é uma anormalidade dos capilares foveais e perifoveais associada à perda das camadas nucleares externas e da zona elipsoide, podendo progredir para lesões císticas (cavitações).
múltiplos DEPS, sugestivo de DMRI
membrana epirretiniana distorcendo o contorno macular

síndrome de tração vítreo-retiniana
O OCT mostra fluido subretiano, com descolamento do epitélio pigmentar (DEP) em formato de “M”, sugestivo de vasculopatia polipoidal
(hiperfluorescência precoce do pólipo à angiografia com indocianina verde)
